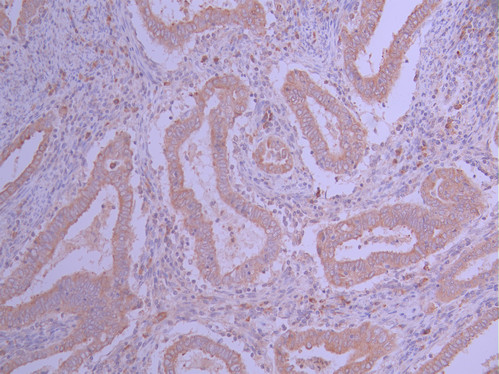

IFNGR1 Recombinant Monoclonal Antibody
-
中文名稱:IFNGR1 Recombinant Monoclonal Antibody
-
貨號:CSB-RA039517A0HU
-
規格:¥1320
-
圖片:
-
IHC image of CSB-RA039517A0HU diluted at 1:100 and staining in paraffin-embedded human endometrial cancer/endometrial carcinoma performed on a Leica BondTM system. After dewaxing and hydration, antigen retrieval was mediated by high pressure in a citrate buffer (pH 6.0). Section was blocked with 10% normal goat serum 30min at RT. Then primary antibody (1% BSA) was incubated at 4°C overnight. The primary is detected by a Goat anti-rabbit polymer IgG labeled by HRP and visualized using 0.05% DAB.
-
Immunofluorescence staining of HepG2 cell with CSB-RA039517A0HU at 1:50, counter-stained with DAPI. The cells were fixed in 4% formaldehyde and blocked in 10% normal Goat Serum. The cells were then incubated with the antibody overnight at 4°C. The secondary antibody was Alexa Fluor 488-congugated AffiniPure Goat Anti-Rabbit IgG(H+L).
-
-
其他:
產品詳情
-
Uniprot No.:
-
基因名:
-
別名:Interferon gamma receptor 1 (IFN-gamma receptor 1) (IFN-gamma-R1) (CDw119) (Interferon gamma receptor alpha-chain) (IFN-gamma-R-alpha) (CD antigen CD119), IFNGR1
-
反應種屬:Human
-
免疫原:A synthesized peptide from human IFNGR1 protein
-
免疫原種屬:Homo sapiens (Human)
-
標記方式:Non-conjugated
-
克隆類型:Monoclonal
-
抗體亞型:Rabbit IgG
-
純化方式:Affinity-chromatography
-
克隆號:16A2
-
濃度:It differs from different batches. Please contact us to confirm it.
-
保存緩沖液:Preservative: 0.03% Proclin 300
Constituents: 50% Glycerol, 0.01M PBS, PH 7.4 -
產品提供形式:Liquid
-
應用范圍:ELISA, IHC, IF
-
推薦稀釋比:
Application Recommended Dilution IHC 1:50-1:200 IF 1:50-1:200 -
Protocols:
-
儲存條件:Upon receipt, store at -20°C or -80°C. Avoid repeated freeze.
-
貨期:Basically, we can dispatch the products out in 1-3 working days after receiving your orders. Delivery time maybe differs from different purchasing way or location, please kindly consult your local distributors for specific delivery time.
-
用途:For Research Use Only. Not for use in diagnostic or therapeutic procedures.
相關產品
靶點詳情
-
功能:Receptor subunit for interferon gamma/INFG that plays crucial roles in antimicrobial, antiviral, and antitumor responses by activating effector immune cells and enhancing antigen presentation. Associates with transmembrane accessory factor IFNGR2 to form a functional receptor. Upon ligand binding, the intracellular domain of IFNGR1 opens out to allow association of downstream signaling components JAK1 and JAK2. In turn, activated JAK1 phosphorylates IFNGR1 to form a docking site for STAT1. Subsequent phosphorylation of STAT1 leads to dimerization, translocation to the nucleus, and stimulation of target gene transcription. STAT3 can also be activated in a similar manner although activation seems weaker. IFNGR1 intracellular domain phosphorylation also provides a docking site for SOCS1 that regulates the JAK-STAT pathway by competing with STAT1 binding to IFNGR1.
-
基因功能參考文獻:
- discovered that a rare variant c.G40A in interferon gamma receptor 1 potentially contributes to the myasthenia gravis pathogenesis PMID: 29441481
- Positive reaction in interferon-gamma release tests is not associated with IFNGR1 SNPs. PMID: 29209098
- All known mutations, as well as 287 other variations, have been deposited in the online IFNGR1 variation database . In this article, we review the function of IFN-gammaR1 and molecular genetics of human IFNGR1. PMID: 28744922
- results showed a significant correlation between IFNGR1- T-56CSNP and Nontuberculous mycobacteria infection among studied populations PMID: 28719321
- B cell type 1 IFN receptor signals accelerate, but are not required for, lupus development. PMID: 27069113
- The study did not provide enough powerful evidence to identify a significant association between IFNGR1 -56C/T polymorphism and tuberculosis susceptibility (meta-analysis). PMID: 25382336
- All patients tested were positive for mycobacteria; one was heterozygous for the IFNGR1 exon 5 single-nucleotide-missense substitution PMID: 27356097
- The deletion of IFNGR1 causes complete IFN-gammaR1 deficiency. Despite the deletion ending very close to the IL22RA2 gene, it does not appear to affect IL22RA2 transcription. PMID: 26931784
- A significant association of IFN-gammaR1 and P2X7 genes polymorphisms with risk of developing TB in Iranian population. PMID: 27020872
- Mendelian susceptibility to mycobacteria due to a partial dominant mutation of the interferon gamma receptor 1 gene. PMID: 26251056
- Targeted deep sequencing identifies rare loss-of-function variants in IFNGR1 for risk of atopic dermatitis complicated by eczema herpeticum PMID: 26343451
- Statistical analyses revealed that four genetic variants in IFNGR1 were marginally associated with the risk of Tuberculosis (P = 0.02-0.04), while other single nucleotide polymorphisms in IFNGR1 and IFNGR2 did not exhibit any associations PMID: 25815589
- FcgammaRIIa cross-talk with TLRs, IL-1R, and IFNgammaR selectively modulates cytokine production in human myeloid cells. PMID: 25108563
- In an African-American population, a significant difference in IFNGR1 expression between patients with RA and controls. However, IFNGR1 expression levels were not statistically significantly associated with erosion status or other radiographic outcomes. PMID: 25708927
- Intact IFN-gammaR1 expression and function distinguishes Langerhans cell histiocytosis from mendelian susceptibility to mycobacterial disease. PMID: 24254535
- Genetic polymorphisms in IFNGR1 gene are involved in the risk of tuberculosis in the Chinese population. PMID: 24680779
- work aimed to evaluate single nucleotide polymorphisms (SNPs) of IFNGR1, GSTT1, and GSTP1 genes samples in gastric cancer PMID: 24453034
- A novel heterozygous frameshift mutation (805delT) encoding the IFN-gamma receptor 1 (IFNGR1) was identified, presenting in a case of Mycobacterium intracellulare infection. PMID: 24220318
- An association study of functional polymorphic genes .... IFNGR-1, ...... with disease progression, aspartate aminotransferase, alanine aminotransferase, and viral load in chronic hepatitis B and C. PMID: 23040881
- Interaction of IFNgammaR1 with TRAF6 regulates NF-kappaB activation and IFNlambdaR1 stability. PMID: 22644879
- A novel endocytosis motif shares characteristics of tyrosine-based and dileucine-based internalization sequences and is highly conserved in IFN-gamma receptors across species. PMID: 22595141
- IFNGR1 is a modifier gene of cystic fibrosis disease. PMID: 21731057
- The Japanese patients with a genetic mutation in the IFN-gamma-R1 gene were more susceptible to developing recurrent disseminated mycobacterial infections. PMID: 21221749
- Single nucleotide polymorphism in IFNGR1 gene is associated with rectal cancer. PMID: 21859832
- CD74 gene over-expression in TEC can increase IFN-gammaR mRNA expression PMID: 21722521
- The autosomal recessive disorder, because of a single mutation in interferon-gamma receptor-1(IFNGR1) at position -56, was found to be associated with susceptibility to leprosy in children of the same family. PMID: 21460021
- IL-29 up-regulated, whereas IFNalpha down-regulated, the surface expression of the IFNgamma receptor 1 chain on macrophages, thereby resulting in differential responsiveness of TLR-challenged macrophages to IFNgamma. PMID: 21190998
- results do not show an implication of IFNGR1gene polymorphisms in the susceptibility to and clinical expression of giant cell arteritis PMID: 20412699
- Clinical trial of gene-disease association. (HuGE Navigator) PMID: 20399512
- study showed a positive association between -56C/C genotype of IFNGR1 (OR = 1.7; 95% CI = 1.1-2.7) and pre-eclampsia. PMID: 20070287
- Functional analysis of naturally occurring amino acid substitutions in human IFN-gammaR1. PMID: 20015550
- A case-control association analysis failed to detect significant association between the IFNGR1 polymorphisms and cerebral malaria in the Thai population PMID: 19712753
- partial IFNGR1 mutations in Japanese patients with BCG osteomyelitis PMID: 11865431
- IFNGR1 gene promoter polymorphisms may be assocaited with susceptibility to cerebral malaria PMID: 12023780
- Mutations in interferon-gamma receptor 1. PMID: 12027427
- This study identified a further role of IFN-gamma on IL-4 responses, including reduced IL-4R surface expression by human monocytes. PMID: 12034035
- Lipid microdomains are required sites for the selective endocytosis and nuclear translocation of IFN-gamma receptor-1. PMID: 12165521
- Partial deficiency of IFN-gamma receptor 1 results in abrogation of IFN-gamma-induced killing of Salmonella typhimurium and Toxoplasma gondii due to IFN-gamma unresponsiveness of patients' cells of the monocyte/macrophage lineage. PMID: 12244188
- FRET was used to demonstrate that the IFNGR chains were preassembled on the cell membrane. PMID: 12438563
- suppressed by 2- to 3-fold in B-cell chronic lymphocytic leukemia cells, which is expected to increase CLL cell survival PMID: 12454749
- Genome analysis identified polymorphism in the human interferon gamma receptor affecting Helicobacter pylori infection. PMID: 12516030
- Mutations have no association with the susceptibility to lepromatous leprosy in the Korean population. PMID: 12743658
- Unidentified allelic variations in the IFNGR1 gene might elevate or decrease the risk in the Croatian population, as a part of the multigenic predisposition to tuberculosis. PMID: 12753505
- In this study, although IFN-gamma production in the allergic patients with L467P was equivalent to that in the non-allergic subjects, their serum IgE levels were high and they had allergic diseases PMID: 12851715
- IFN-gamma receptor deficiency alters the epitope hierarchy of the pool of lymphocytic choriomeningitis virus-specific memory CD8 T cells without significantly affecting the immunodominance of the primary CD8 T cell response in an acute infection. PMID: 14734726
- disease susceptibility in Schistosoma mansoni infection to hepatic fibrosis is linked to a SNP in the interferon gamma receptor locus (P=0.000001). PMID: 15756299
- The IFN-GammaR2 Arg64/Arg64 genotype does not determine susceptibility to SLE in Chinese people, and the combination of IFN-Gamma R2 Arg64/Arg64 genotype and IFN-Gamma R1 Val14/Val14 genotype does not, either. PMID: 15952126
- The relationship between polymorphisms at IFNGR1 and susceptibility to pulmonary tuberculosis is reported in Iranian patients. PMID: 16233916
- IFNGR1 does not contribute to susceptibility to rheumatoid arthritis in Caucasians, although a single nucleotide polymorphisms exist in this disease. PMID: 16563189
- Novel tuberculosis association was found with the 56CC genotype of the IFNGR1 promotor. PMID: 16690980
顯示更多
收起更多
-
相關疾病:Immunodeficiency 27A (IMD27A); Immunodeficiency 27B (IMD27B)
-
亞細胞定位:Cell membrane; Single-pass type I membrane protein.
-
蛋白家族:Type II cytokine receptor family
-
數據庫鏈接:
Most popular with customers
-
-
YWHAB Recombinant Monoclonal Antibody
Applications: ELISA, WB, IHC, IF, FC
Species Reactivity: Human, Mouse, Rat
-
Phospho-YAP1 (S127) Recombinant Monoclonal Antibody
Applications: ELISA, WB, IHC
Species Reactivity: Human
-
-
-
-
-